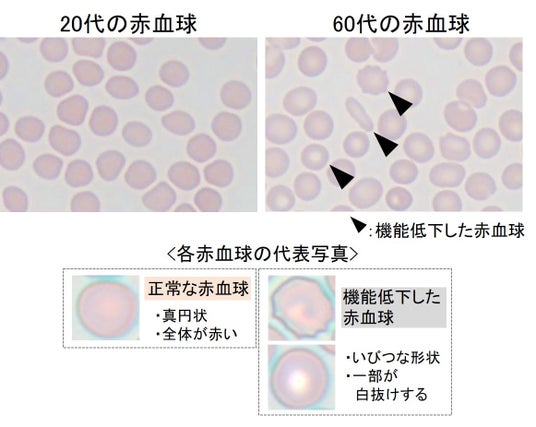

霊芝の胞子油に造血幹細胞を増やす効果を発見
日本メナード化粧品 総合研究所ケイヒ、高麗人参と組み合わせることで疲労改善効果を確認
日本メナード化粧品株式会社(愛知県名古屋市中区丸の内3-18-15、代表取締役社長:野々川 純一)は、長年研究を続けてきた生薬の一つ「霊芝」の胞子から抽出した油(霊芝胞子油)に、赤血球を作り出す造血幹細胞を増やす効果があることを発見しました。さらに、霊芝胞子油に古くから知られている生薬であるケイヒと高麗人参の抽出物を組み合わせると、造血幹細胞から赤血球の産生が促進されることが分かりました。これらの結果から、この3種の生薬抽出物により体内の造血系を活性化させることで、疲労改善効果につながると期待されました。そこで今回、この3種の生薬抽出物を3か月間飲用してみたところ、疲労改善効果があることを確認しました。

メナードはこれまでに、加齢に伴う疲労の蓄積に血液の状態が関係していると考え研究を進めてきました。その結果、血液中に機能低下した赤血球の割合が増加すると、身体が疲れやすくなることを発見しました。また、機能低下した赤血球が増える原因として、加齢で増加する「IL-1α」と呼ばれる炎症性タンパク質が、造血幹細胞からの新しい赤血球の産生を妨げており、それが大きく影響していることを突き止めました(*1)。
この研究結果から、根本的な疲労の改善には、新しい赤血球を増やし、機能低下した赤血球の割合を下げる必要があると考えました。そこで今回、新しい赤血球を増やす効果がある生薬の探索を行いました。その結果、古くから健康増進の生薬として珍重されている「霊芝」の胞子から抽出した油(霊芝胞子油)に造血幹細胞を増殖させる効果を発見しました。さらに、「ケイヒ」の抽出物に造血幹細胞から新しい赤血球の産生を促進する効果を、「高麗人参」の抽出物にIL-1αの分泌を抑制する効果を見出しました。
そして今回、この3種の生薬抽出物を3か月間飲用することで、生体内のIL-1αの減少とともに機能低下した赤血球の割合が減少し、合わせて疲労度が改善することも確認できました。この結果は、造血幹細胞から赤血球の産生を促進することによる、新しい疲労改善のアプローチとして期待されます。今後は、有効成分の特定を進めつつ、根本的な疲労改善を目指した技術開発へとつなげてまいります。
なお、本研究の成果は2024年8月24日から25日にかけて千葉で開催された第41回和漢医薬学会学術集会にて発表しました。
*1 : ニュースリリース 「加齢に伴う疲れやすさに赤血球の機能低下が関与することを発見」
https://prtimes.jp/main/html/rd/p/000000064.000048666.html
<参考資料>
1.疲れやすさと赤血球の関係
疲労の原因の1つは体内のエネルギー源であるATP(Adenosine triphosphate)の低下によって引き起こされると考えられています。このATPの産生には酸素が重要で、その酸素は赤血球によって全身の細胞へ運搬されます。赤血球はストレス、活性酸素、加齢などの影響で機能が低下し、酸素を運ぶ能力が低下します。機能が低下した赤血球が増えると、酸素の運搬が減少し、ATPの産生が低下してエネルギーが不足し、疲労しやすくなります。実際に疲労の指標である自律神経活動量と赤血球の機能の関連性を解析すると、機能低下した赤血球の割合が大きいほど疲れやすくなることが分かりました(図1)。

機能低下した赤血球の割合比較(加齢群と若齢群)
20代と60代の赤血球観察例

疲れやすさと赤血球の関係 グラフ

疲れやすさと赤血球の関係 イメージ
図1 疲れやすさと赤血球の関係
2.新しい赤血球を生み出す3種の生薬
造血幹細胞は、赤血球の元となる幹細胞です。造血幹細胞は増殖(分裂)し、その一方が赤血球に変わる(分化する)ことで、新しい赤血球を生み出します。新しく生み出された赤血球が機能低下した赤血球と置き換わることで酸素を運ぶ能力が回復し、赤血球としての機能が維持されています(図2)。

図2. 造血幹細胞による赤血球の新生
つまり、新しい赤血球を作り出すためには、造血幹細胞を増やし、分化させることが必要になります。そこで今回、造血幹細胞の増殖と分化を促進する生薬の探索を進めました。その結果、これまでも古くから人々の健康を支え、珍重されてきた生薬の一つである「霊芝」の胞子から抽出した油(霊芝胞子油)に造血幹細胞を増殖させる効果を発見しました(図3左)。また、その他に「ケイヒ」の抽出物に造血幹細胞から赤血球への分化を促進する効果を見出しました(図 3 右)。


図3. 生薬抽出物による造血幹細胞の増殖と赤血球への分化促進効果
また、メナードではこれまでに、老化した細胞から分泌されるIL-1αという炎症性タンパク質が、造血幹細胞の増殖と赤血球への分化を妨げることを発見しており(図4)、このIL-1αの分泌を抑制する生薬の探索も行いました。

図4. 造血幹細胞の増殖と赤血球への分化を阻害するIL-1α
その結果、「高麗人参」の抽出物に、IL-1αの分泌を抑制する効果を発見しました(図5)。

図5. 生薬抽出物によるIL-1α分泌抑制効果
これら3種の生薬抽出物を組み合わせることで、新しい赤血球を増やし、機能低下した赤血球の割合を減少させ、疲れやすさを改善できると考えられました。
3.3種の生薬抽出物を配合した飲料の飲用による疲労の改善効果
今回発見した3種の生薬抽出物を含有した飲料を、健康な被験者(男性32名、女性10名、平均年齢40.9歳)に3か月間飲用してもらい、飲用前後の赤血球の状態と疲労について解析を行いました。その結果、飲用によって、IL-1αの分泌が抑えられ、機能低下した赤血球の割合が減少しました(図6)。さらに主観的な疲労感や運動負荷時(エアロバイクで5分間運動)の疲労度についても改善が認められました(図7)。
以上のことから、今回発見した3種の生薬抽出物を含有した飲料は、造血幹細胞の赤血球産生を促し、赤血球機能を改善することで疲労を改善する効果が期待されます。


図6. 3種の生薬抽出物によるIL-1αの分泌抑制と赤血球の機能改善


※1 VAS(Visual analogue scale)
主観的な症状を視覚的に表す手法。10cmの線分の任意の位置をマークし現在の症状を数値化する。
※2 Total power
心拍データから算出される自律神経の活性を表す数値で疲労度の指標として知られている。自律神経活動量が低下すると疲労していることを示す。
図7. 3種の生薬抽出物による疲労改善効果
<3種の生薬>
〇霊芝胞子霊芝はマンネンタケ科のキノコで、中国の古い薬学書である「神農本草経」に、その不老長寿効果が掲載されている伝統的な生薬です。
メナードは1980年頃から研究を行っており、これまでにも健康維持に役立つ効果を発見し発表してきました。その中でも、胞子は霊芝の種子ともいえるものです。

霊芝胞子
〇ケイヒ中国南部からベトナムにかけてが原産とされるクスノキ科の常緑樹である「桂(けい)」の樹皮を乾燥させたもの。香辛料のシナモン、あるいはニッキとして親しまれています。健康維持に役立つ生薬で、世界中で親しまれています。

ケイヒ
〇高麗人参オタネ人参や朝鮮人参とも呼ばれる、ウコギ科の多年生植物の根の太い部分。健康に良い生薬として、霊芝同様に、中国の古い薬学書である「神農本草経」に掲載されています。

高麗人参
企業プレスリリース詳細へ
PR TIMESトップへ